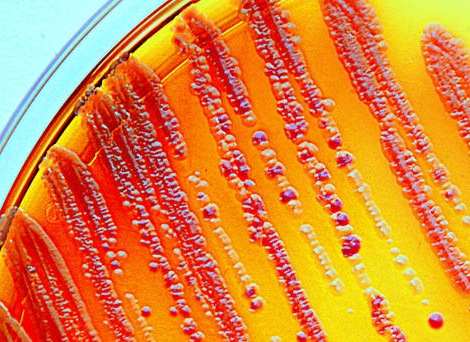
Lutte contre l’antibiorésistance : ce que peut apporter la dispensation à l’unité

Matthieu Vandendriessche
Matthieu Vandendriessche est docteur en pharmacie et journaliste pour la presse pharmaceutique depuis une vingtaine d’années. En dehors du secteur officinal, il exerce également une activité de conseil et de formateur dans le domaine de la gérontologie.
Tous les articles de Matthieu Vandendriessche (1906)

Publicité



Publicité
Publicité
- Rémunération des pharmaciens : une réforme majeure se prépare-t-elle ?
- Vaccination antigrippale en pharmacie : vacciner dès maintenant, oui ou non ?
- Les métiers de l’officine enfin reconnus à risques ergonomiques
- Salaires et nouvelle grille des coefficients : le compte à rebours a commencé
- Remises génériques : l’arrêté rectificatif en passe d’être publié
- Comptoir officinal : optimiser l’espace sans sacrifier la relation patient
- Reishi, shiitaké, maitaké : la poussée des champignons médicinaux
- Budget de la sécu 2026 : quelles mesures concernent les pharmaciens ?
- Cancers féminins : des voies de traitements prometteuses
- Vitamine A Blache 15 000 UI/g : un remplaçant pour Vitamine A Dulcis